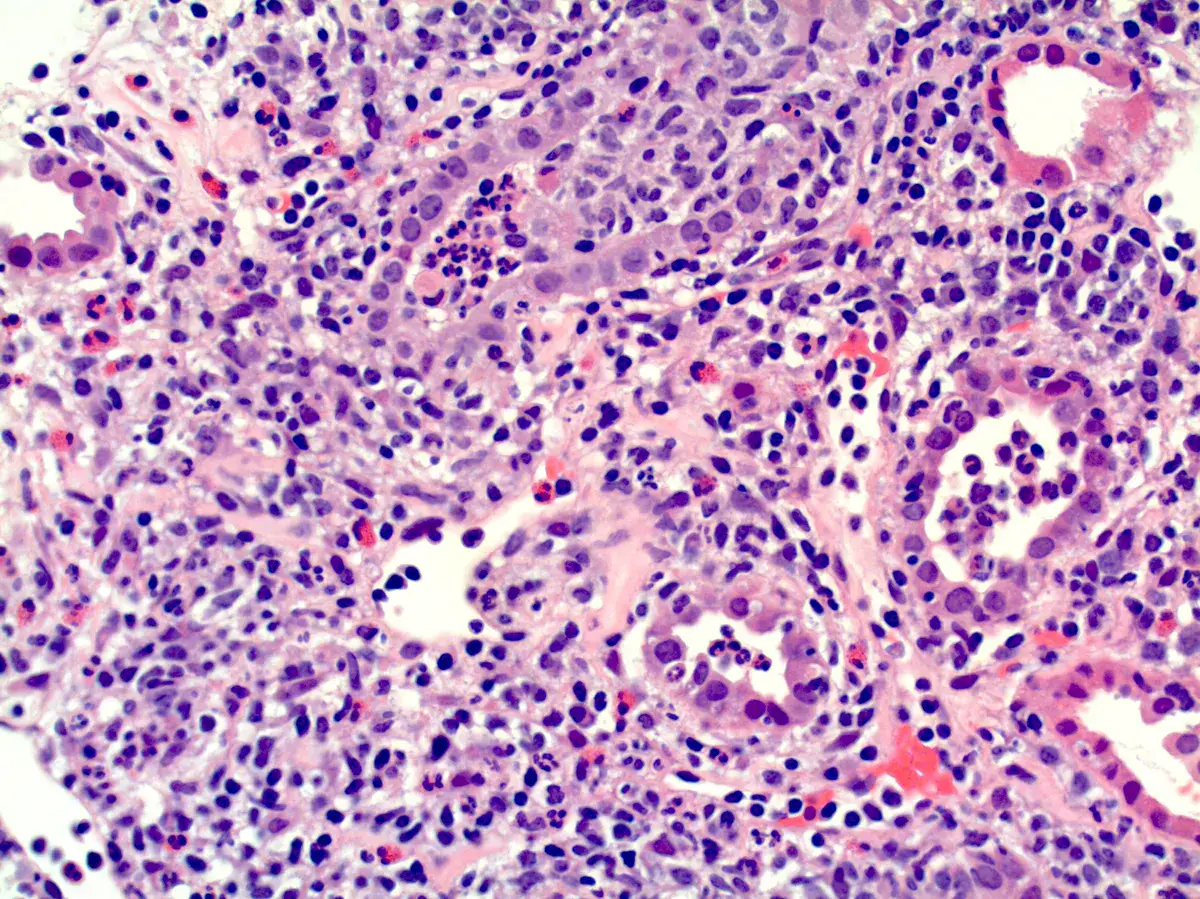
Quando e como prescrever corticoide na NIA?

Calcifilaxia: o que realmente muda sua prática no diagnóstico e manejo?
Nunca é fácil conduzir um paciente com diagnóstico de Calcifilaxia, confere essas dicas de diagnóstico e tratamento que fazem diferença no manejo!
Luís Sette
3 meses atrás
93 artigos

Nunca é fácil conduzir um paciente com diagnóstico de Calcifilaxia, confere essas dicas de diagnóstico e tratamento que fazem diferença no manejo!
Luís Sette
3 meses atrás

Dor lombar súbita e hipotensão em um paciente que o nefrologista é chamado para auxilar na investigação, quais pontos importantes do diagnóstico não podemos esquecer?
Valkercyo Feitosa
4 meses atrás

DRC “indeterminada” raramente é falta de diagnóstico — quase sempre é falta de método. Tempo de evolução, urina bem avaliada, USG renal e história clínica dirigida mudam conduta e evitam erros comuns na prática nefrológica.
Luís Sette
6 meses atrás

Hipercalciúria não é diagnóstico — é um sinal. Antes de rotular como “idiopática”, diferenciar hipercalcemia vs. normocalcemia e investigar causas tubulares, hormonais e granulomatosas muda conduta, prognóstico e evita DRC.
Luís Sette
6 meses atrás

Icterícia intensa + AKI progressiva? Veja além do hepatorrenal: o sedimento conta a história. Compartilhe com colegas que valorizam o raciocínio clínico refinado.
Valkercyo Feitosa
6 meses atrás

Antes de investigar adenomas, investigue o armário da cozinha. O pseudo-hiperaldosteronismo induzido por alcaçuz deve fazer parte do raciocínio nefrológico diante de hipocalemia associada à hipertensão.
Valkercyo Feitosa
7 meses atrás

A semaglutida, amplamente usada para perda de peso, pode raramente desencadear rabdomiólise — um risco ainda pouco reconhecido na prática clínica. Este caso mostra a relação temporal clara entre titulação acelerada e lesão muscular grave.
Valkercyo Feitosa
7 meses atrás

Hematúria pós infecção, caso clínicos para auxiliar no entendimento de causas glomerulares comuns e raras...
Valkercyo Feitosa
8 meses atrás

No congresso ASN 2025 foram apresentadas terapias inovadoras para Nefropatia da IgA com destaque para ensaios fase 3, estratégias de diálise em pacientes com Insuficiência Renal Aguda (IRA) e o ensaio PISCES demonstrou que suplementação diária com óleo de peixe reduziu eventos cardiovasculares em hemodiálise. Prepare-se para um mergulho rápido nas mudanças de conduta que vêm por aí!
Luís Sette
8 meses atrás

Já ouviu falar em lesão renal causada por fumaça de solda? Confere esse caso clínico interessante para amentar nosso repertório diagnóstico em casos de IRA sem etiologia bem definida.
Valkercyo Feitosa
9 meses atrás

A glomerulonefrite por C3 (GNC3) resulta de ativação descontrolada da via alternativa do complemento e pode simular uma GN pós-infecciosa. O diagnóstico correto depende do reconhecimento do padrão de deposição de C3 e da investigação genética. Com terapias-alvo como o eculizumabe e o iptacopan, identificar precocemente a GNC3 pode mudar o desfecho do paciente.
Luís Sette
9 meses atrás

Síndrome cardiorrenal representa a intersecção entre coração e rins, onde a disfunção de um órgão agrava o outro. U0001F6A8 Post voltado a nefrologistas, abordando diagnóstico precoce e manejo integrado para reduzir mortalidade e internações.
Luís Sette
9 meses atrás

Hipercalcemia em DRC no pós-artroplastia: e se o vilão não for o PTH? Pistas discretas — 1,25(OH)₂D↑, ECA↑ e PET “quente” na prótese — apontam para ASIA por cimento ósseo. Acompanhe o raciocínio que faz o diagnóstico emergir e muda a conduta.
Valkercyo Feitosa
10 meses atrás

A descoloração do cateter de diálise peritoneal nem sempre indica peritonite. No caso relatado, o achado estava relacionado à transferência de corante de roupas sintéticas. A exclusão sistemática de infecção e a educação do paciente evitam tratamentos desnecessários.
Valkercyo Feitosa
10 meses atrás

Proteinúria persistente, dor neuropática e lesões cutâneas podem parecer desconexas, mas, quando analisadas em conjunto, revelam a Doença de Fabry. Este caso ilustra como a integração entre clínica, biópsia renal, estudo enzimático e genética conduz a um diagnóstico preciso e a um manejo precoce, com impacto direto no prognóstico do paciente e de sua família.
Valkercyo Feitosa
11 meses atrás

Você sabia que a voclosporina, embora mais segura que a ciclosporina, pode causar hiperplasia gengival? Esse relato inédito muda nossa vigilância com pacientes em uso do fármaco. Leia o resumo completo no post da semana!
Valkercyo Feitosa
11 meses atrás

Hidroxicloroquina na IgA gestacional: evidência promissora? Dois casos clínicos recentes mostram melhora da proteinúria com o uso de HCQ em pacientes com NIgA durante a gestação. Uma alternativa segura quando iSRA e SGLT2i estão contraindicados. Vale a pena conhecer!
Valkercyo Feitosa
12 meses atrás

Você ainda trata toda gamopatia monoclonal com creatinina normal como “MGUS”? Nem sempre é tão simples. O conceito de MGRS mudou a forma de enxergar a paraproteína: mesmo em pequenas quantidades, ela pode ser nefrotóxica.
Valkercyo Feitosa
12 meses atrás

GESF corticorresistente em adultos: quando insistir, parar ou investigar genética? A decisão terapêutica na GESF corticorresistente exige equilíbrio: até onde ir com imunossupressores e quando considerar mutações genéticas como causa?
Luís Sette
12 meses atrás

Microcistos renais e lítio: existe relação? O uso crônico de lítio pode impactar os rins, mas qual o papel dele na formação de microcistos renais? Entenda o que a literatura recente revela.
Valkercyo Feitosa
12 meses atrás

Finerenona no contexto de piora aguda da função renal: o que os novos dados mostram? Estudo recente avalia eficácia e segurança do uso da finerenona mesmo diante de elevações transitórias da creatinina. Entenda como interpretar esse achado na prática clínica e quando manter ou suspender o tratamento.
Luís Sette
12 meses atrás

Vai pulsar com metilprednisolona? Confira os cuidados essenciais antes de iniciar a pulsoterapia: Um checklist rápido e prático para garantir segurança na prescrição!
Luís Sette
12 meses atrás

Você já viu um efluente de diálise vermelho? U0001F6A8 Neste caso surpreendente, a coloração da bolsa ajudou a confirmar um diagnóstico crítico. Saiba como diferenciar causas, conduzir o caso e evitar armadilhas diagnósticas.
Valkercyo Feitosa
13 meses atrás
Nefrite Intersticial Aguda (NIA) é uma das causas reversíveis de injúria renal aguda. O uso de corticoides pode acelerar a recuperação da função renal, mas deve ser criterioso. Saiba quando e como prescrever com segurança.
Luís Sette
2 anos atrás

Hematuria e perda rápida da função renal em pacientes com câncer devem levantar suspeita de trombose da veia renal, mesmo sem contraste. Imagens não contrastadas e Doppler podem ser ferramentas-chave nesse contexto.
Valkercyo Feitosa
2 anos atrás

O tratamento da disfunção no paciente com insuficiência cardíaca não é nada fácil! Vamos para uma sessão de questões desafios para discutir pontos essenciais no tratamento!
Luís Sette
2 anos atrás

Sabe aqueles casos que aparecem no final do plantão do nefrologista? confere situações corriqueiras, mas que temos que estar atentos para condutas adequadas!
Luís Sette
2 anos atrás

Sabe aqueles casos que aparecem no final do plantão do nefrologista? confere situações corriqueiras, mas que temos que estar atentos para condutas adequadas!
Luís Sette
2 anos atrás

Toda vez ficamos naquela dúvida se devemos ou não liberar o nosso paciente para realização de exames que utilizam o Gadolínio macrocíclico, qual tem sido a sua conduta?
Luís Sette
2 anos atrás

Sempre somos questionado sobre a liberação para uso de medicamentos naturais, que não temos como garantir a procedência. Confere esse caso pitoresco, mas muito edicativo!
Valkercyo Feitosa
2 anos atrás

U0001F50E Resistência a Diuréticos na Doença Renal Crônica: o que fazer quando o edema não responde? O uso de diuréticos é rotina no manejo da congestão na DRC, mas o que explica os casos em que a resposta é ineficaz? Neste post, discutimos os principais mecanismos de resistência, estratégias de otimização do tratamento e quando considerar combinações ou abordagens alternativas.
Luís Sette
2 anos atrás

Infecção por Salmonella em Transplantado Renal: quando o comum vira complexo Mesmo agentes típicos podem causar quadros graves em pacientes imunossuprimidos. Neste post, discutimos um caso real, sinais de alerta e condutas essenciais.
Valkercyo Feitosa
2 anos atrás

Como Iniciar Insulina de Forma Prática e Segura pelo Nefrologista? U0001FA78U0001F489 A insulinização em pacientes com doença renal crônica (DRC) exige cuidados especiais para evitar hipoglicemias e otimizar o controle glicêmico. Como escolher o melhor esquema?
Luís Sette
2 anos atrás

O primeiro xenotransplante renal humano trouxe desafios inéditos para a nefrologia. Como foi o manejo clínico? O que levou ao óbito do paciente? Confira a análise deste caso revolucionário!
Valkercyo Feitosa
2 anos atrás

A IC e a IRA frequentemente coexistem, criando uma complexa interação chamada síndrome cardiorrenal: mas será que toda vez que o paciente evolui com elevação de creatinina devemos nos preocupar? confere esse artigo que fala sobre a importância da descongestão!
Luís Sette
2 anos atrás

Descubra como o sotagliflozina pode mudar o manejo de um caso de hipomagnesemia severa e refratária. Saiba mais sobre este avanço terapêutico e seu impacto prático na nefrologia moderna!
Valkercyo Feitosa
2 anos atrás

Descubra como a hipereosinofilia pode revelar rejeição mediada por anticorpos em uma paciente transplantada renal após falência do enxerto. Um caso que destaca o papel dos eosinófilos no diagnóstico diferencial e manejo clínico!
Valkercyo Feitosa
2 anos atrás

Este caso destaca a importância de considerar causas menos comuns, como a insuficiência adrenal, em pacientes com hipotensão intradialítica persistente. Para nefrologistas, a avaliação de cortisol e ACTH deve ser incluída no diagnóstico diferencial de hipotensão refratária em pacientes em hemodiálise, contribuindo para a personalização do manejo e redução da morbimortalidade.
Valkercyo Feitosa
2 anos atrás

A síndrome de lise tumoral espontânea desafia o manejo de nefrologistas em pacientes oncológicos com IRA. Confere essa dica para um diagnóstico mais precoce que pode mudar o desfecho clínico.
Valkercyo Feitosa
2 anos atrás

Hiponatremia em pacientes com HIV: diagnóstico diferencial e manejo no blog NefroUpdates!
Valkercyo Feitosa
2 anos atrás

Febre e dor no flanco: pielonefrite ou infarto renal? Saiba como identificar os sinais radiológicos que fazem a diferença no diagnóstico e garantem o tratamento correto!
Valkercyo Feitosa
2 anos atrás

Como você procederia investigação nessa paciente? Confere o diagnóstico!
Valkercyo Feitosa
2 anos atrás

Descubra como o diagnóstico precoce da necrose cortical renal pode mudar o curso da lesão renal aguda em contextos críticos. Leia mais sobre este caso desafiador e suas implicações práticas para nefrologistas.
Valkercyo Feitosa
2 anos atrás

IRA com ascite: Deve ser uma síndrome hepatorrenal, certo? Descubra como uma perfuração vesical após radioterapia pode simular lesão renal aguda e aprenda a identificar esse raro diagnóstico diferencial em nefrologia
Valkercyo Feitosa
2 anos atrás

O manejo da Nefrite Lúpica em paciente com Síndrome Antifosfolípide pode ser desafiador. Confere esse post com dicas importantes no manejo
Luís Sette
2 anos atrás

Dica interessante quando estamos diante de um paciente com SIDA em piora de função renal após início do tratamento com os antirretrovirais
Valkercyo Feitosa
2 anos atrás

Caso clínico muito interessante mostrando a importância das profilaxias no transplante renal e apresentação atípica de doenças comuns!
Valkercyo Feitosa
2 anos atrás

O manejo da hipercalemia crônica no paciente com DRC pode ser desafiador. Confere esse post sobre medidas práticas para abordagem da hipercalemia no paciente com DRC
Luís Sette
2 anos atrás

Caso interessante para quem avalia pacientes oncológicos, sempre ficar atento aos efeitos adversos relacionados ao tratamento quimioterápico
Valkercyo Feitosa
2 anos atrás

Podemos utilizar acetazolamida nos pacientes em diálise? Muito cuidado!
Valkercyo Feitosa
2 anos atrás

Fístula urinária como complicação de um cateter uretral, vale a pena a leitura dessa caso clínico publicado no NEJM
Valkercyo Feitosa
2 anos atrás

Já ouviu falar da Síndrome do roubo coronário-subclávio? e insuficiência cardíaca de alto-débito relacionada a FAV?
Valkercyo Feitosa
3 anos atrás

Diante de pacientes com múltiplos tumores de células renais claras devemos pensar na possibilidade de doença de Von-Hippel Lindau. O tratamento visando poupar massa renal pode fazer muita diferença
Valkercyo Feitosa
3 anos atrás

Um caso clínico muito bonito para entendersmo a fisiopatologia da hipertensão renovascular. Não deixa de conferir!
Valkercyo Feitosa
3 anos atrás

Frequentemente nos deparamos com pacientes que evoluem com quadro de IRA "desproporcional" ao quadro séptico, necrose cortical renal é uma entidade que não pode ser esquecida, principalmente em pacientes com complicações obstétricas
Valkercyo Feitosa
3 anos atrás

Caso interessante que poderia passar batido com DRC de etiologia indeterminada. Casos como esse mostram a importância de realização de biópsia renal em pacientes com IRA sem etiologia bem definida
Valkercyo Feitosa
3 anos atrás

Confere esse caso clínico sobre uma causa importante de IRA em pacientes com HIV doença
Valkercyo Feitosa
3 anos atrás

Podemos utilizar os análogos dos receptores GLP-1 para tratar obesidade na DRC dialítica? confere essas dicas rápidas para individualizar duas condutas
Valkercyo Feitosa
3 anos atrás

Já ouviu falar em calcinose tumoral, nesse relato de caso interessante apresenta pontos importantes para diagnóstico e manejo
Valkercyo Feitosa
3 anos atrás

Sessão de desafio diagnóstico do NEJM que nos adiciona muito conhecimento sobre o tema vasculite!
Valkercyo Feitosa
3 anos atrás

Caso clínico simples que mostra pontos chaves na condução de infecções graves em transplantados renais
Valkercyo Feitosa
3 anos atrás
.webp)
Segue esse caso clínico que chama atenção para uma causa incomum, mas prevenível de trombose de enxerto renal
Valkercyo Feitosa
3 anos atrás

A apresentação clínica de uma gamopatia monoclonal de significado renal é muito ampla. Confere esse caso clínico para ampliar seu entendimento sobre as gamopatias monoclonais
Valkercyo Feitosa
3 anos atrás

Confere esse caso de mudança de coloração no efluente do dialisato em um paciente em diálise contínua
Valkercyo Feitosa
3 anos atrás

Já ouviu falar sobre malacoplaquia renal, confere esse caso!
Valkercyo Feitosa
3 anos atrás

Diante de um angiomiolipoma renal, como saber diferenciar se tratar de uma causa esporádica ou faz parte do Complexo Esclerose Tuberosa? Confere essa dica
Valkercyo Feitosa
3 anos atrás

Um caso interessante sobre infecção urinária de repetição!
Valkercyo Feitosa
3 anos atrás

A central de transplante oferta um rim e nos deparamos com doador portador de rim em ferradura, será que devemos negar a oferta?
Valkercyo Feitosa
3 anos atrás

Mais um caso clínico para gravar e aumentar nosso diagnóstico diferencial diante de pacientes com nódulos cutâneos e doença renal
Valkercyo Feitosa
3 anos atrás

A investigação de disfunção renal em transplantado de órgãos sólidos pode ser desafiadora. Confere esse caso de infecção por BK em transplantado cardíaco
Valkercyo Feitosa
3 anos atrás

Febre, nódulo pulmonar e granuloma renal em um transplantado renal
Valkercyo Feitosa
3 anos atrás

Olha esse caso clínico fora do dia a dia do nefrologista, mas que temos que estar atentos para saber conduzir de forma adequada
Valkercyo Feitosa
3 anos atrás

Dores ósseas podem ser de difícil identificação etiológica. Confere esse caso clínico com uma causa atípica de dor em transplantado renal
Valkercyo Feitosa
3 anos atrás

Nada mais desafiador do que definir etiologia de um paciente com IRA e hepatite. Confere esse caso clínico muito interessante
Valkercyo Feitosa
3 anos atrás

Caso típico de GNRP em paciente idosos. Vendo a imagem, qual seria sua primeira hipótese diagnóstica?
Valkercyo Feitosa
3 anos atrás

Mais um caso clínico para ler e fixar, o que pensar diante de um paciente com hipercalcemia e adenopatia?
Valkercyo Feitosa
3 anos atrás

Nefrotoxicidade por drogas é sempre um desafio na investigação de lesão renal. Confere esse caso clínico
Valkercyo Feitosa
3 anos atrás

Confere esse caso clínico para gravar a síndrome genética
Valkercyo Feitosa
3 anos atrás

Desafio diagnóstico, qual seria as hipóteses diagnósticas diante desta imagem?
Valkercyo Feitosa
3 anos atrás

Algumas vezes nos deparamos com hipocalemia e não sabemos como organizar a investigação. Confere esse Quiz do AJKD
Valkercyo Feitosa
3 anos atrás

Tema que o dia a dia do Nefrologista. Confere o resumo deste importante artigo de revisão.
Luís Sette
3 anos atrás

Confere essa imagem para gravar e não esquecer quanto estiver diante de um quadro de ITU complicada!
Valkercyo Feitosa
3 anos atrás

Frequentemente avaliamos no consultório paciente com cistos renais, o que pensar diante de um paciente com múltiplos microcistos? Confere esse caso!
Valkercyo Feitosa
3 anos atrás

Por que contraindicamos o uso de vitamina C no paciente com DRC dialítica? Confere esse caso clínico no NEJM
Valkercyo Feitosa
3 anos atrás

Confere esse caso clínico para aumentar o leque diagnóstico na investigação de uma IRA
Valkercyo Feitosa
3 anos atrás

Dor lombar e Hematúria, quase sempre é nefrolitíase, certo? Confere esse caso clínico para aumentar hipóteses diagnósticas!
Valkercyo Feitosa
3 anos atrás

Esta é uma complicação rara do tratamento da osteoporose, porém temos que estar atentos para prevenção!
Valkercyo Feitosa
3 anos atrás

Diversas são as causas de IRA, temos que ter muita atenção para não nos contentarmos com casos de IRA sem etiologia definida. Confere esse caso peculiar.
Valkercyo Feitosa
3 anos atrás

Sempre devemos ter atenção aos efeitos colaterais dos medicamentos mais comumente utilizados. Checa esse caso clínico!
Valkercyo Feitosa
3 anos atrás

Caso clínico interessante para chamar nossa atenção para uma causa de IRA pós renal
Valkercyo Feitosa
3 anos atrás

Confere esse caso clínico sobre rebaixamento do sensório e alucinação em paciente dialítico.
Valkercyo Feitosa
3 anos atrás

Caso clínico muito interessante de uma causa de IRA que podemos deixar passar batido no nosso dia a dia.
Valkercyo Feitosa
3 anos atrás

Caso clínico sobre IgA para ficarmos de olho nas possibilidades de evolução clínica.
Valkercyo Feitosa
3 anos atrás
Explore Nossos Cursos Especializados e Inscreva-se Agora para Avançar em sua Carreira e Beneficiar seus Pacientes